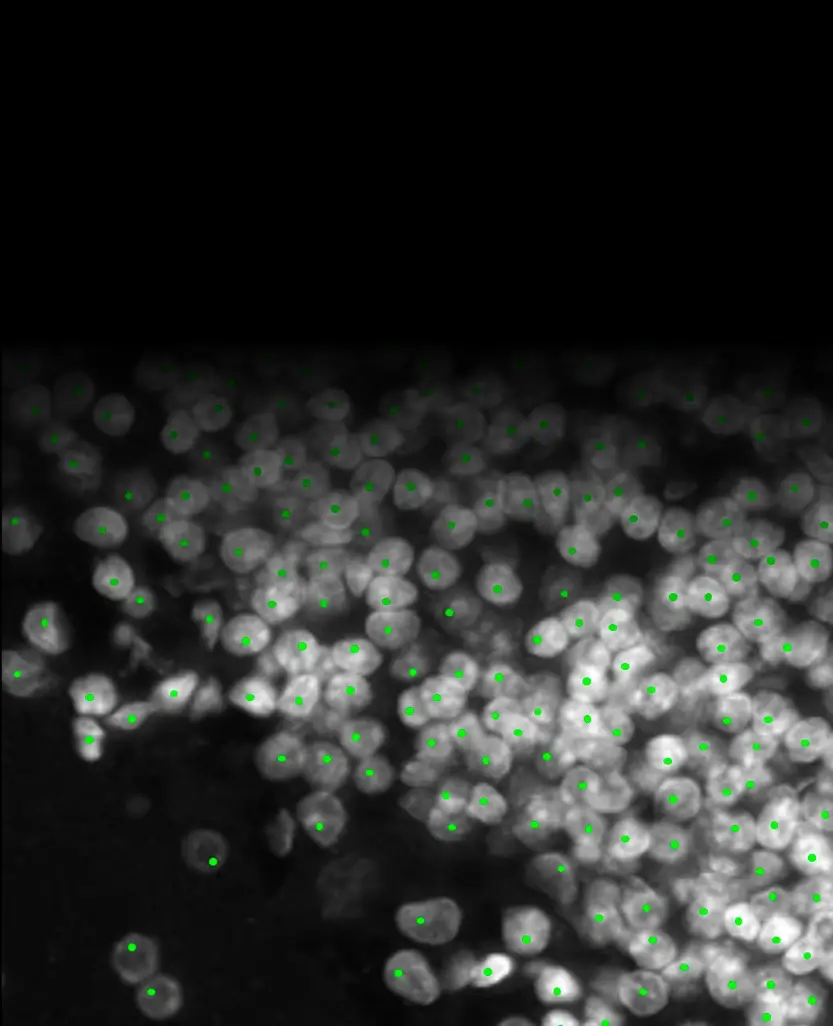
Automated cell detection with green markers on nuclei

Atlas-Mapped Brain Slice Scanning
PanoBrain is an automated platform for brain slice imaging and atlas mapping, designed to accelerate high-throughput neuroscience workflows. Developed by Meca Scientific, PanoBrain transforms prepared tissue sections into high-resolution, atlas-registered digital datasets with minimal manual intervention — bridging the gap between bench and analysis.

- Automated panoramic imaging that preserves full anatomical context across entire tissue sections
- Reproducible, high-throughput acquisition with integrated atlas mapping for large-scale studies
- Analytical workflows that eliminate manual stitching and region-of-interest bias
- Seamless integration with existing histology pipelines and third-party analysis tools
Core Capabilities

Automated Imaging and Analysis Pipeline
- Fully automated transition from brain slices to quantitative digital datasets
- Integrated hardware and software pipeline minimizes operator intervention and variability
- Designed to support batch processing of large slide sets
AI-Assisted Brain Mapping and Quantification
- Automated brain region segmentation and atlas registration
- Compatibility with standard reference frameworks (e.g., Allen Brain Atlas)
- Built-in tools for automated cell counting and fluorescence intensity quantification
High-Speed, Large-Format Imaging
- Widefield scanning optimized for rapid, whole-slice acquisition — under one minute per section
- Supports large-format slides (up to 125 x 50 mm), enabling full imaging of large brain sections
- Precision XYZ motion platform (0.1 um) for accurate, repeatable positioning
Multi-Modal and Multi-Color Imaging
- Brightfield and multi-channel fluorescence imaging modes
- Supports complex, multi-label experiments for detailed cellular and circuit-level analysis
- Sub-micron resolution suitable for identifying individual neurons and fine structures
- Highly uniform illumination across the full field of view for seamless panoramic images
- Low-phototoxicity imaging enabled by exposure-synchronized illumination control
Multi-Species Atlas Registration
PanoBrain supports automated atlas registration across four species, mapping scanned sections to standardized anatomical coordinates with a single click:




Robust Registration on Imperfect Samples
Real-world brain sections are rarely perfect. PanoBrain’s atlas registration handles damaged, fragmented, and tilted slices without manual correction:



Panolyzer Analysis Software

Panolyzer provides integrated analysis tools including atlas registration, brain region segmentation, automated cell counting, and multi-point localization. The software displays scanned sections with atlas boundaries overlaid, a 3D brain reference with Bregma coordinates, and tools for fluorescence channel switching, signal adjustment, and quantitative measurement.
Research Applications
- Whole-brain and regional circuit mapping
- Viral tracing and connectivity studies
- Quantitative pathology and neurodegeneration research
- Drug efficacy and regional response analysis
Integrated Analysis Workflows
PanoBrain delivers atlas-registered datasets ready for advanced analysis. Explore how it integrates with ScientiaLux analysis platforms:
- PanoBrain + StrataQuest — Spatial phenotyping and quantitative tissue analysis
- PanoBrain + MIKAIA — AI-driven digital pathology
- StrataQuest Glossary — 66 terms on detection, measurement, and spatial analysis
- Imaging Glossary — Optical fundamentals and acquisition parameters

